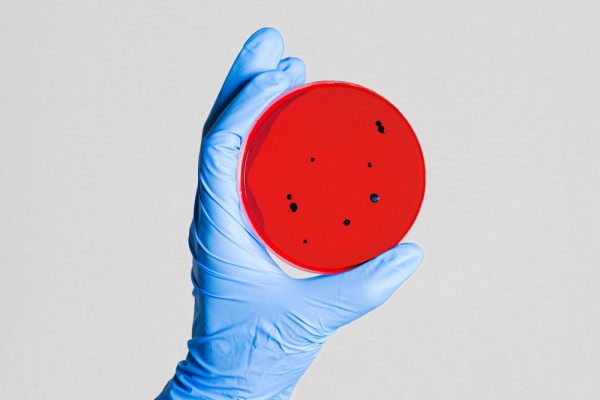

На данный момент в Украине зарегистрировано всего 78 261 официальных лабораторно подтвержденных случаев коронавируса. За сутки количество пациентов с COVID-19 увеличилось на 1453 человека - это новый антирекорд по суточному числу заболевших за все время пандемии в стране.
По статистике МОЗ:
- умерли – 1 852 человека (+33 за сутки);
- выздоровели - 43 055 пациентов (+531 за сутки);
- активные случаи - болеют 33 354 украинцев.
За все время пандемии в стране было проведено более одного миллиона 135 тысяч ПЦР-тестов. Всего было получено более 132 тысяч сообщений о подозрении на COVID-19.
Все случаи коронавируса
Больше всего новых случаев заражения выявили в Львовском (152), Ивано-Франковском (131), Харьковском (146), Одесском (156), Ровенском (100) регионах и в Киеве (186). За последние сутки в каждой области страны выявили новых заболевших.
Львовский, Черновицкий, Ровенский, Закарпатский, Ивано-Франковский регион и Киев остаются самыми первыми в рейтинге, где зафиксировано наибольшее количество случаев COVID-19 - больше пяти тысяч. Во Львовской области число инфицированных за время время пандемии превысило 10 тысяч.
- Киев - 9178;
- Винницкая область - 2932;
- Волынская область - 4162;
- Днепропетровская область - 1508;
- Донецкая область - 945;
- Житомирская область – 2064;
- Закарпатская область – 5615;
- Запорожская область – 895;
- Ивано-Франковская область - 5426;
- Киевская область - 4058;
- Кировоградская область - 714;
- Луганская область - 146;
- Львовская область – 10572;
- Николаевская область – 682;
- Одесская область - 3904;
- Полтавская область - 489;
- Ровенская область - 6638;
- Сумская область – 636;
- Тернопольская область - 3212;
- Харьковская область - 4527;
- Херсонская область – 255;
- Хмельницкая область - 1286;
- Черкасская область - 975;
- Черниговская область - 965;
- Черновицкая область - 6477.
Коронавирус в Киеве
За последние сутки в столице коронавирус лабораторно подтвердился еще у 186 человек, среди которых 11 детей. Летальных случаев, к счастью, не было, а выздоровели 26 жителей.
На сегодня уже 9178 подтвержденных случаев заболевания COVID-19, выздоровевших - 3163 пациента, в умерших - 142 человека. Сейчас болеют 5900 киевлян.
Заболели в Киеве:
- 94 женщины в возрасте от 19 до 84 лет,
- 81 мужчина в возрасте от 19 до 70 лет,
- 7 девочек от 2 до 16 лет,
- 4 мальчика от 1 года до 13 лет.
В больницы столицы госпитализировали 20 пациента. Другие - на самоизоляции, под контролем врачей.
Больше всего случаев заболевания за прошедшие сутки обнаружили в Дарницком районе – 47, в Деснянском – 30 и в Святошинском – 20 случаев.
Полностью выздоровели
В общей сложности выздоровели более 43 тысяч человек. Повторное лабораторное исследование показало отрицательные результаты и не подтвердило наличие коронавируса.
За последние сутки вылечились 531 пациент. Наибольшее число - в Львовском (87), Ивано-Франковском (58), Черновицком (51) и в Тернопольском (52) регионах. Выздоровевших пациентов не было только в Черниговской и Днепропетровской области.
- Киев – 3163;
- Винницкая область –2190;
- Волынская область - 3126;
- Днепропетровская область - 1132;
- Донецкая область - 724;
- Житомирская область - 1518;
- Закарпатская область - 2341;
- Запорожская область - 640;
- Ивано-Франковская область – 1988;
- Киевская область - 2902;
- Кировоградская область - 648;
- Львовская область - 2822;
- Луганская область - 115;
- Николаевская область - 477;
- Одесская область - 1391;
- Полтавская область - 345;
- Ровенская область - 5139;
- Сумская область - 391;
- Тернопольская область - 1989;
- Харьковская область - 2399;
- Херсонская область - 213;
- Хмельницкая область - 1001;
- Черкасская область - 760;
- Черниговская область - 564;
- Черновицкая область – 5077.
Умерли из-за коронавируса
Из-за осложнений, вызванных COVID-19, скончались 1 852 украинца. За последние сутки умерли 33 человека в Сумской, Николаевской, Кировоградской, Винницкой, Тернопольской, Одесской, Волынской, Харьковской, Ивано-Франковской, Закарпатской, Ровенской, Черновицкой и Львовской областях.
- Киев - 142;
- Винницкая область - 58;
- Волынская область - 90;
- Днепропетровская область - 31;
- Донецкая область - 13;
- Житомирская область - 40;
- Закарпатская область - 216;
- Запорожская область - 21;
- Ивано-Франковская область - 150;
- Киевская область - 67;
- Кировоградская область - 38;
- Львовская область - 294;
- Луганская область - 1;
- Николаевская область - 15;
- Одесская область - 65;
- Полтавская область - 15;
- Ровенская область – 103;
- Сумская область - 9;
- Тернопольская область - 41;
- Харьковская область - 138;
- Херсонская область - 3;
- Хмельницкая область - 25;
- Черкасская область - 37;
- Черниговская область - 18;
- Черновицкая область - 222.
Согласно данным Университета Джона Хопкинса, по состоянию на утро 7 августа, Украина находится на 34 месте из 188 стран в рейтинге по количеству подтвержденных случаев. На соседних ступеньках разместились Израиль и Доминиканская Республика.
В мире зафиксировано больше 19 миллионов человек с COVID-19 (19 101 222). За сутки цифра увеличилась на 287 тысяч. Больше всего заболевших находятся в США, Бразилии и Индии - как минимум два миллиона человек.
В общей сложности умерли 715 013 человек - количество возросло на семь тысяч за сутки, а больше 11,5 миллионов пациентов выздоровели (11 551 370) – 189 тысяч.
Лидирующие страны с коронавирусом
- США - 4 миллиона 883 тысячи,
- Бразилия – 2 миллиона 912 тысяч,
- Индия - 2 миллиона 27 тысячи,
- Россия – 870 тысячи,
- Южная Африка – 538 тысяч.
По количеству смертей первые места в рейтинге у США, где отметка уже превысила 160 тысяч, Бразилии (98 тысяч) и Мексики (50 тысяч). Больше всего пациентов выздоровели в Бразилии (2 миллиона 230 тысяч), которая занимает первую строку в рейтинге, потом в Америке (1 миллион 598 тысяч) и Индии (1 миллион 378 тысяч).
Чтобы предотвратить распространение коронавируса, рекомендуется соблюдать несколько правил:
- меньше выходить на улицу;
- избегать контакта с людьми;
- соблюдать дистанцию между людьми с симптомами ОРВИ - больше 1,5 метра;
- избегать скопления людей в лифтах и подъездах. Если все-таки оказались в лифте, то желательно держать максимальную дистанцию между людьми;
- не трогать руками лицо, особенно нос, рот и глаза;
- термически обрабатывать продукты во время приготовления пищи;
- часто и тщательно мыть руки с мылом на протяжении 20-40 секунд;
- если нет возможности помыть руки, желательно использовать 60% спиртовой антисептик;
- прикрывать рот и нос салфеткой или согнутым локтем во время кашля или чихания;
- при проявлении первых симптомах ОРВИ - обращаться к семейному врачу.
Теги: здоровье , украина , смерть , статистика , люди , коронавирус , заболевание , пандемия